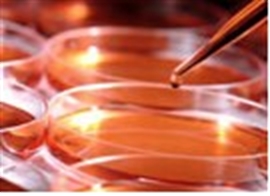

Reporter: Aviva Lev-Ari, PhD, RN
Cancer Diagnostics by Genomic Sequencing: ‘No’ to Sequencing Patient’s DNA, ‘No’ to Sequencing Patient’s Tumor, ‘Yes’ to focus on Gene Mutation Aberration & Analysis of Gene Abnormalities
How to Tailor Cancer Therapy to the particular Genetics of a patient’s Cancer
THIS IS A SERIES OF FOUR POINTS OF VIEW IN SUPPORT OF the Paradigm Shift in Human Genomics
‘No’ to Sequencing Patient’s DNA, ‘No’ to Sequencing Patient’s Tumor, ‘Yes’ to focus on Gene Mutation Aberration & Analysis of Gene Abnormalities
PRESENTED in the following FOUR PARTS. Recommended to be read in its entirety for completeness and arrival to the End Point of Present and Future Frontier of Research in Genomics
Part 1:
Research Paradigm Shift in Human Genomics – Predictive Biomarkers and Personalized Medicine
http://pharmaceuticalintelligence.com/2013/01/13/paradigm-shift-in-human-genomics-predictive-biomarkers-and-personalized-medicine-part-1/
Part 2:
LEADERS in the Competitive Space of Genome Sequencing of Genetic Mutations for Therapeutic Drug Selection in Cancer Personalized Treatment
http://pharmaceuticalintelligence.com/2013/01/13/leaders-in-genome-sequencing-of-genetic-mutations-for-therapeutic-drug-selection-in-cancer-personalized-treatment-part-2/
Part 3:
Personalized Medicine: An Institute Profile – Coriell Institute for Medical Research
http://pharmaceuticalintelligence.com/2013/01/13/personalized-medicine-an-institute-profile-coriell-institute-for-medical-research-part-3/
Part 4:
The Consumer Market for Personal DNA Sequencing
http://pharmaceuticalintelligence.com/2013/01/13/consumer-market-for-personal-dna-sequencing-part-4/
Part 3:
Personalized Medicine: Institute Profile – Coriell Institute for Medical Research
Coriell Institute for Medical Research, founded in 1953 and based in Camden, New Jersey, is an independent non-profit research center dedicated to the study of the human genome. Expert staff and pioneering programs in the fields of personalized medicine, cell biology, cytogenetics, genotyping, and biobanking drive our mission.
The emerging field of personalized medicine draws upon a person’s genomic information to tailor treatments and prescription drug dosing to optimize health outcomes. The Coriell Personalized Medicine Collaborative® (CPMC®) research study is seeking to understand the usefulness of genetic risk and pharmacogenomics in clinical decision-making and healthcare management.
Coriell has a distinguished history in cell biology. We are building upon this expertise by playing an important role in induced pluripotent stem (iPS) cell research. Induced pluripotent stem cells are powerful cells which can be made from skin or blood cells, and they are revolutionizing the way human disease is studied and how drugs are developed. Skin cells from a patient diagnosed with heart disease are being genetically reprogrammed into stem cells, and then transformed into beating cardiac cells. Researchers can now examine the heart-diseased cells to better understand the progression of heart disease and develop treatments and cures. Drug efficacy and safety can also be tested in this laboratory environment, providing an efficient model of drug discovery that delivers drugs to patients sooner. This technology, called “disease in a dish,” offers researchers the potential to study the myriad of human diseases, including Alzheimer’s disease, muscular dystrophy, and diabetes.
In addition to pioneering cutting-edge research initiatives, Coriell offers custom research services – including cell culture, cytogenetic analyses, and molecular biology – to the scientific community. Furthermore, Coriell’s Genotyping and Microarray Center is one of the nation’s largest centers, with high-throughput DNA analysis, CLIA-certified genotyping platforms systems from Illumina and Affymetrix.
Essential to the Institute’s support of international scientific research is the Coriell Biobank. From this renowned cell bank, we manage and distribute the world’s most diverse collection of cell lines, DNA, and other biological resources. The Coriell Biobank provided support to the Human Genome Project, a worldwide program to map the entire human genome, and to the International HapMap Project, a project providing an efficient tool to identify disease-causing genes.
The Coriell Cell Repositories provide essential research reagents to the scientific community by establishing, verifying, maintaining, and distributing cell cultures and DNA derived from cell cultures. These collections, supported by funds from the National Institutes of Health (NIH) and several foundations, are extensively utilized by research scientists around the world.
The Business Aspects of the Institute
DNA, Genes, and SNPs
What is the CPMC Study?
CPMC Technology
CPMC FAQs
CPMC Advisors and Partners
Stem Cells
Induced Pluripotent Stem (iPS) Cells
iPS Cell Research at Coriell
Biobank Catalog
Working with Coriell
Overview
Biobanking
Cell Culture
Cytogenetics
Genotyping & Microarray
Molecular Biology
Research Design & Expertise
Stem Cells
Quality at Coriell
Overview
What is a Biobank?
How Coriell Banks Cells
Biobank Technology
Biobank Catalog
Working with Coriell
http://www.coriell.org/
http://www.coriell.org/assets/pdfs/discover-winter2012.pdf
http://www.ccr.coriell.org/
http://www.coriell.org/about/coriell-faqs
What is the Coriell Institute of Medical Research?
Founded in 1953, Coriell Institute for Medical Research is an independent, non-profit research organization dedicated to the study of the human genome and to supporting national and international research by providing biomaterials from its renowned biobank.
How did the Coriell Institute start?
Lewis L. Coriell, MD, PhD, a virology researcher and pediatrician, recognized the need for scientific research that would translate into better patient care. After seeing how his research helped to bring the Salk vaccine to polio patients across our nation, Dr. Coriell founded the South Jersey Medical Research Foundation. It was renamed the Institute for Medical Research in 1966 to recognize its broader reach, and, in 1985, to honor Dr. Coriell’s retirement, his name was added. For a look at our history, visit our timeline.
http://www.coriell.org/about/our-history
About the Founder
“You set up an experiment to test the theory, and most of the time it’s not the way you thought it would be. But that’s the way you learn. You go from hypothesis to hypothesis. And it’s exciting because that’s the way we learn to treat, to diagnose, and to prevent illness.”
Lewis L. Coriell, MD, PhD
Virologist and Pediatrician
June 19, 1911 – June 19, 2001
Lewis L. Coriell was born in the farming community of Sciotoville, in southern Ohio. While he was still a young child, his family moved to Montana toward more promising agricultural opportunities. It has been written that “the aspects of character, personality, temperament, and intellect that marked Dr. Coriell’s exceptional professional life… can easily be traced to his Montana upbringing.”i
Education and Early Career
Beginning his academic journey at the University of Montana, Lewis Coriell completed undergraduate studies in biology and subsequently earned a master’s degree in bacteriology and immunology in 1936. That same year, he married fellow student Ester Lentz; they would remain by each other’s side for the next 60 years. The newlyweds moved to the University of Kansas so he could pursue doctoral studies in immunology. While there, Dr. Coriell published his first article on an aspect of science he would revolutionize: The storage of cells by freezing them. Lewis Coriell earned his doctorate in 1940 and was awarded his medical degree in 1942. The young researcher was drawn to the field of virology – the study of viruses as they evolve and infect. At this time, bacterial infections presented themselves most often in children. This combination led Dr. Coriell to seek out a residency in pediatrics. As none were immediately available, he chose a cardiology residency at Henry Ford Hospital in Detroit. MI. As it happens, the Coriells’ time in Detroit was brief.
By 1943, World War II was raging and Dr. Coriell was called to service with the United States Army Medical Command’s Biological Research Division at Fort Detrick, MD. It was here that his research in cell cultivation began. After the war, Dr. Coriell began his ideal pediatric residency under Dr. Joseph Stokes, Jr., physician-in-chief at Children’s Hospital of Philadelphia (CHOP). To his delight, Dr. Stokes placed great emphasis on research and was instrumental in attracting federal funds to research childhood disease at his institution. The ability to translate research into patient care inspired Dr. Coriell. He saw how research was essential to the treatment of his patients suffering the devastating effects of viruses like small pox, mumps, and polio.
Adventures in Cell Culture
By the time Dr. Coriell arrived in Philadelphia, virologists knew they had to grow viruses in cell culture to prepare purified viruses for the manufacture of vaccines. However, contamination was rife in the laboratory and proving to be a major obstacle. At CHOP, along with his colleagues, Dr. Coriell perfected the technique to culture human tissue in a sterile host that does not produce its own antibodies. The ability to sustain living human cells in culture, and keep them from being contaminated, led to a key breakthrough in polio research – it enabled scientists to grow the polio virus and work toward the first vaccine.
Moving to Camden and Taking on Polio
By the early 1950’s, an acute infectious disease called polio was spreading from person to person very quickly across the United States, striking fear into citizens, costing children their lives and crippling those who survived. In 1949, Dr. Coriell arrived in Camden, NJ, as medical director of Camden Municipal Hospital, one of the country’s last infectious disease hospitals and home to the majority of the region’s polio patients. In 1951, Dr. Coriell was appointed field director of the Polio Prevention Study and directed the successful gamma globulin field trials.
By 1954, the Salk polio vaccine could be made in large quantities and was ready for human clinical trials. Based on his success shepherding the gamma globulin field trials, Dr. Coriell was chosen by the National Poliomyelitis Foundation to evaluate the Salk polio virus vaccine clinical trials in New Jersey, Pennsylvania, Maryland, and Virginia. The success of the evaluation program led to the release of the Salk vaccine on the national level. Before the trials began in 1955, approximately 20,000 new polio cases were being reported each year. By 1960, cases were reduced to 3,000 per year. By 1979, that number was just 10 each year. Recognizing his contribution, Dr. Coriell received the 1957 International Poliomyelitis Congress Presidential Medal. Soon after, he became chairman of the Committee on the Control of Infectious Diseases of the American Academy of Pediatrics which formulated the vaccination procedures for all children in this critical period.
In 1953, Dr. Coriell initiated a campaign to build the first non-profit academic medical research institute in South Jersey. Under his guidance, the Institute for Medical Research began research in cancer, human cytogenetics, infectious diseases, and methods to improve cell culture techniques. The history of the Institute’s accomplishments included Dr. Coriell’s foresight in calling for the establishment of a central tissue culture bank and cell registry to certify and maintain cell cultures. It began with a partnership with the National Institutes of Health to create the first standardized cell repository. Today, the Institute is home to the world’s most diverse collection of cell lines and DNA samples available to researchers.
Working with his colleague, Dr. Gary McGarrity, Dr. Coriell applied infection control technology – specifically laminar flow – to create the laminar flow hood that is vital to infection control in laboratories, operating rooms, and hospital rooms around the world.
Dr. Coriell’s pioneering techniques for characterizing, freezing, and storing non-contaminated cell cultures in liquid nitrogen constitute one of the greatest contributions to modern human genetics.
Retirement
Dr. Coriell retired in 1985. To honor the occasion, the institute he founded was renamed the Coriell Institute for Medical Research. He remained involved in several ways, as a member of the board and often speaking with groups about the Institute’s history. Following his retirement, Dr. Coriell was elected president of the prestigious College of Physicians of Philadelphia, the oldest medical society in America. Dr. Coriell is the only New Jersey physician to receive this honor.
Dr. Coriell, a pioneering researcher and physician, died on June 19, 2001, in Southern New Jersey. It was his 90th birthday.
A Legacy in Science
Dr. Coriell’s accomplishments in science are indeed many. Perhaps Dr. Coriell’s most enduring legacy was his generosity in knowledge and his ability to bring scientists together to explore research questions and collaborate on solutions. Several important names in science were drawn to join or spend time at the Institute; they included Warren W. Nichols, Ray Dutcher, Richard Mulivor, Etienne Lasfargues, Jesse Charney, Arthur Greene, Daniel Moore, and collaboration with Drs. Albert Levan and Joe Hin Tijo, who first discovered that humans have 46 chromosomes.
Dr. Coriell also created an institute that is a well-respected resident of the Greater Philadelphia region and known as a leader in research worldwide.
Coriell Today
Dr. Coriell’s vision is now our vision. Today, Coriell staff and scientists collaborate on scientific ideas and programs to improve human health.
The Coriell Personalized Medicine Collaborative® research study is studying the utility of using your genetic information to tailor treatments and medications for you. And building on Dr. Coriell’s innovations in cell biology, we are playing an important role in cutting-edge stem cell research to unlock the code of human disease, including Parkinson’s and heart disease. Coriell offers a range of custom research services that have long supported national and international science. In the field of biobanking, Coriell supports research all over the world from its renowned and diverse cell collections.
Our innovation today is a testament to Dr. Coriell’s pioneering past. More importantly, our innovation is a commitment to your future.
i O’Donnell, John. Coriell; The Coriell Institute for Medical Research and a Half Century of Science. Massachusetts: SHP, 2002.
Where is the Coriell Institute located?
Coriell is located at 403 Haddon Avenue, Camden, NJ 08103. For directions, click here
We recommend that you park at 3 Cooper Plaza, a parking garage associated with the hospital, located directly across the street from Coriell. There is also a second hospital parking lot located on Benson Street, which is a block from the Institute.
For what is the Coriell Institute known?
Coriell Institute is a leader in the emerging field of personalized medicine – often called genome-informed medicine – which is the practice of using genetic information to better understand a patient’s risk for disease and response to medications. The Coriell Personalized Medicine Collaborative is a research study designed to study the utility of genetic information in clinical decision-making and patient care.
Coriell is also playing an important role in exploring the promise of induced pluripotent stem (iPS) cell biotechnologies. [Pluripotent refers to how cells can grow into many different types of cells.] We can take skin cells and reprogram them – essentially turn back time – to behave like a stem cell. These cells can then be triggered, using specific proteins, to become cardiac cells, neurons (brain cells), or insulin-producing pancreatic cells, amongst others. Over the years, Coriell has developed an extraordinary expertise in the culture of human cells, and much of the standard practices in cell culture were developed at Coriell. This includes the techniques for freezing and thawing cells, and sterile handling of cultures. As a result of our cell biology expertise, scientists from every major research center in the world draw upon the Coriell Cell Repositories, maintained in the world’s leading biobank, which contains cell lines and DNA representing approximately 650 diseases.
Who is on the Coriell Institute staff?
Coriell is home to approximately 120 scientific and operational staff. Michael Christman, PhD, is Coriell’s President and CEO; he is an expert in genomics and genetics. Joseph L. Mintzer is Coriell’s Executive Vice President and COO and manages the fiscal and operational aspect of the institute. Meet the rest of the Coriell leadership team here.
Who is on the Coriell Institute Board of Trustees?
Coriell is guided by a diverse Board of Trustees that includes corporate, medical, financial, and philanthropic leaders. Chairman of the Coriell Board is Robert P. Kiep III. Learn more about the Coriell Board of Trustees here.
How is Coriell Institute funded?
Coriell Institute has an annual operating budget of $17 million, about $11 million of which comes from federally- and state-funded grants and contracts. Private and corporate philanthropy provides the seed money to initiate new programs in science at Coriell – science that has the opportunity to advance discoveries in research which may not be occurring at other research institutes.
How can I support the research mission of Coriell Institute?
While the majority of Coriell’s operating revenue is derived from federally- and state-funded grants and contracts, the Institute also relies on private, foundation, and corporate philanthropy. Your support can advance the emerging field of personalized medicine to improve the practice of medicine. Your support also allows Coriell to pursue and support research in adult stem cell biology and genomics seeking to unlock the code of human disease.
There are many ways to give to Coriell: Outrights gifts, through your workplace giving programs, planned giving, volunteering your time and expertise, or attending or hosting a Coriell event. Visit our fund development page to learn more about how you can support scientific research.
How does Coriell Institute support international research?
The Coriell Cell Repositories offers essential research materials to the scientific community by establishing, verifying, maintaining, and distributing cell cultures and DNA. Since the first NIH-sponsored repository was established in 1964 – Coriell has distributed hundreds of thousands of cell lines and DNA samples to researchers in 64 countries. More than 7,000 peer-reviewed papers have been published citing almost 12,000 Coriell Repository samples.
What research services does Coriell Institute provide?
Coriell offers several best-in-class custom research services.
Coriell’s Genotyping and Microarray Center – one of the nation’s largest centers and CLIA-certified in 48 states – is a high-capacity facility with high-throughput systems from Affymetrix and Illumina.
The Coriell Institute Cytogenetics Laboratory is a state-of-the-art facility that combines conventional and molecular cytogenetic analyses with copy number and loss of heterozygosity (LOH) analyses by microarray. The laboratory is equipped with a network of five Applied Spectral Imaging work-stations that are used to perform G-banded karyotyping, and Fluorescent In Situ Hybridization (FISH).
Coriell also offers many preparative and diagnostic nucleic acid and molecular biology services, all subject to extensive quality controls.
And, the Coriell biobank is regarded as the most diverse collection of cell lines and DNA available to the international research community.
Does Coriell Institute engage in gene therapy or stem cell clinical trials?
Coriell Institute does not pursue research using human embryonic stem cells, nor do we conduct clinical trials on stem cell technologies. If you are interested in gene therapy or stem cell-related clinical trials, please visit http://www.clinicaltrials.gov.
What education does Coriell offer?
Coriell offers a course in cell culture: Advanced biology coupled with the history, theory, and techniques of maintaining live cells in long-term culture is offered to students.
Coriell also invites a limited number of motivated students into the Institute to participate in a Summer Experience program to gain insight into the workings of an independent research institute
How can I stay informed on what is happening at Coriell Institute?
Sign up for our email updates and you’ll receive periodic research news, notable donations, and upcoming events. Visit our Media Center regularly to read the latest news articles and Coriell press releases.
How can I get a quick overview of Coriell Institute?
Read our Coriell Fast Facts for a basic introduction to the Institute. For more information, explore the About section of our website.
Are Coriell Institute scientists and staff available for speaking engagements?
As their schedules permit, Coriell’s scientific and operational staffs enjoy the opportunity to highlight the work occurring at Coriell. Many hold joint faculty appointments at our region’s universities and teach an array of topics from business management and healthcare policy to the science of cell culture and stem cell research.
Coriell also participates in several outreach programs each year, including science festivals and conferences. We also host tours of our laboratories for business and governmental leaders and middle school and high school students.
16. Is Coriell Institute affiliated with Cooper Medical School of Rowan University?
Yes; Coriell is looking forward to welcoming the new medical school and will be integral in teaching genetics and genomics to the next generation of healthcare providers.

The Power of Stem Cell Science
The promise of stem cell research lays in its application in understanding the progression of human disease, the ability to cure disease and reverse injury, and to better target therapies to optimize our health outcomes. Induced pluripotent stem (iPS) cell technology has the ability to revolutionize the way human disease is studied. Creating iPS cell lines from various rare and common disease states, as well as from various populations, will open the doors for pre-clinical research studies.

Let Our Expertise Make Your Research a Success
Coriell offers a range of custom research services that have long supported national and international science. Whether you are requesting a cell line for your research studies or submitting DNA samples for genotyping analysis, Coriell is committed to providing you with flexible, innovative, and results-oriented research services. Our laboratories are built to foster scientific collaboration, and your research will benefit from this collaborative environment.
Coriell’s Biobank and Cell Culture Laboratory have established the gold standard in the cryopreservation of biomaterials and the capacity to support varied research worldwide. The diverse collections of biological specimens managed by Coriell offer the scientific community the highest quality specimens, which are necessary for successful research endeavors. Since the first repository – a National Institutes of Health collection – was established at Coriell in 1964, hundreds of thousands of cell lines and DNA samples have been distributed to researchers in 64 countries; more than 7,000 peer-reviewed papers have been published citing almost 12,000 biospecimens from the Coriell Biobank.

Making Medicine Personalized for You
Our health is determined by many factors: the genetics we inherit; our innate personal traits of race, age and gender; our individual behavior; our family and community networks; and at the macro level, our economic, cultural, and environmental conditions. These factors are different for every person and will change over their lifespan. So too is a person’s experience with disease and how they respond to drugs or other medical interventions. Personalized medicine intends to make medical treatment as individual as the biology of one’s disease.
Personalized medicine has the potential to offer patients and their doctors several advantages, including:
The ability to make better informed clinical decisions.
A higher probability of desired health outcomes by using better-targeted therapies.
The reduced probability of adverse reactions from medications and treatments.
A focus on prevention and prediction of disease, rather than reaction to it.
Earlier disease intervention.
Reduced healthcare costs.

Preserving cells today for research tomorrow
Dr. Lewis Coriell’s pioneering techniques for characterizing, freezing, and storing cell cultures in liquid nitrogen constitute one of the greatest contributions to modern human research. Today, the Coriell Biobank is regarded as the most diverse collection of cell lines and DNA available to the international research community. In addition to these high-quality biospecimens, Coriell also maintains tissue, plasma, serum, urine, and cerebrospinal fluid.
Few organizations have the history of innovations in repository science that have been developed and implemented at Coriell. For nearly 60 years, Coriell has set the standard in biobanking services, including the experimental design, collection, processing, distribution, cryogenic preservation, and information management of human biomaterials used in research. By developing and maintaining biorepositories as national and international resources for the study of human diseases, aging, and neurological disease, Coriell is committed to providing the scientific community with well-characterized, cell cultures and DNA preparations, annotated with rich phenotypic data.
Catalog Collections
NIGMS Human Genetic Repository
The Human Genetic Cell Repository, sponsored by the National Institute of General Medical Sciences, provides scientists around the world with resources for cell and genetic research. The samples include highly characterized cell lines and high quality DNA. Repository samples represent a variety of disease states, chromosomal abnormalities, apparently healthy individuals and many distinct human populations.
NINDS Human Genetics DNA and Cell Line Repository
The National Institute of Neurological Disorders and Stroke is committed to gene discovery, as a strategy for identifying the genetic causes and correlates of nervous system disorders. The NINDS Human Genetics DNA and Cell Line Repository banks samples from subjects with cerebrovascular disease, epilepsy, motor neuron disease, Parkinsonism, and Tourette Syndrome, as well as controls.
NIA Aging Cell Repository
Sponsored by the National Institute on Aging (NIA), the AGING CELL REPOSITORY, is a resource facilitating cellular and molecular research studies on the mechanisms of aging and the degenerative processes associated with it. The cells in this resource have been collected over the past three decades using strict diagnostic criteria and banked under the highest quality standards of cell culture. Scientists use the highly-characterized, viable, and contaminant-free cell cultures from this collection for research on such diseases as Alzheimer disease, progeria, Parkinsonism, Werner syndrome, and Cockayne syndrome.
NHGRI Sample Repository for Human Genetic Research
The National Human Genome Research Institute (NHGRI) led the National Institutes of Health’s (NIH) contribution to the International Human Genome Project, which had as its primary goal the sequencing of the human genome. This project was successfully completed in April 2003. Now, the NHGRI’s mission has expanded to encompass a broad range of studies aimed at understanding the structure and function of the human genome and its role in health and disease.
American Diabetes Association, GENNID Study
The purpose of the American Diabetes Association (ADA), GENNID Study (Genetics of non-insulin dependent diabetes mellitus, NIDDM) is to establish a national database and cell repository consisting of information and genetic material from families with well-documented NIDDM. The GENNID Study will provide investigators with the information and samples necessary to conduct genetic linkage studies and locate the genes for NIDDM.
The Autism Research Resource
The State of New Jersey funded the initiation of a genetic resource to support the study of autism in families where more than one child is affected or where one child is affected and one demonstrates another significant and related developmental disorder. This resource now receives continuing support from the Coriell Institute for Medical Research. An open bank of anonymously collected materials documented by a detailed clinical diagnosis forms the basis of this growing database of information about the disease.
IPBIR Repository
The purpose of the IPBIR – Integrated Primate Biomaterials and Information Resource is to assemble, characterize, and distribute high-quality DNA samples of known provenance with accompanying demographic, geographic, and behavioral information in order to stimulate and facilitate research in primate genetic diversity and evolution, comparative genomics, and population genetics.
HD Community BioRepository
HD Community BioRepository is a secure, centralized repository that stores and distributes quality-controlled, reliable research reagents. Huntingtin DNAs are now available and antibodies, antigenic peptides, cell lines, and hybridomas will be added soon.
USIDNET Repository
The USIDNET DNA and Cell Repository has been established as part of an NIH-funded program – the US Immunodeficiency Network (www.usidnet.org) – to provide a resource of DNA and functional lymphoid cells obtained from patients with various primary immunodeficiency diseases. These uncommon disorders include patients with defects in T cell, B cell and/or granulocyte function as well as patients with abnormalities in antibodies/immunoglobulins, complement and other host defense mechanisms.
CDC Cell and DNA Repository
The Genetic Testing Reference Material Coordination Program of the Centers for Disease Control and Prevention (CDC) and the Coriell Institute for Medical Research announce the availability of samples derived from transformed cell lines for use in molecular genetic testing. The DNA samples prepared from these reference cell lines are available through the Coriell Cell Repositories. Diseases include cystic fibrosis (CF), 5′ 10′ methylenetetrahydrofolate reductase deficiency (MTHFR), HFE-associated hereditary hemochromatosis, Huntington disease (HD), fragile X syndrome, Muenke syndrome, connexin 26-associated deafness, and alpha-thalassemia.
Leiomyosarcoma Cell and DNA Repository
The Leiomyosarcoma Cell and DNA Repository has been established with an award from the National Leiomyosarcoma Foundation. This foundation provides leadership in supporting research of Leiomyosarcoma, improving treatment outcomes of those affected by this disease as well as fostering awareness in the medical community and general public.
COHORT Project
The Cooperative Huntington’s Observational Trial Repository has been established as a resource for the discovery of information related to Huntington’s disease and its causes, progressioin, treatments, and possible cures. This is a growing bank for DATA and SPECIMENS to accelerate research on Huntington’s disease.
YERKES Repository
The Yerkes National Primate Research Center of Emory University is an international leader in biomedical and behavioral research. For more than seven decades, the Yerkes Research Center has been dedicated to advancing scientific understanding of primate biology, behavior, veterinary care and conservation, and to improving human health and well-being.
NEI-AREDS Genetic Repository
The Age-Related Eye Disease Study was designed to learn about macular degeneration and cataract, two leading causes of vision loss in older adults. The study looked at how these two diseases progress and what their causes may be. In addition, the study tested certain vitamins and minerals to find out if they can help to prevent or slow these diseases. Participants in the study did not have to have either disease. (Enrollment was completed in January 1998.) Eleven medical centers in the United States took part in the study, and more than 4,700 people across the country were enrolled in AREDS. The study was supported by the National Eye Institute, part of the Federal government’s National Institutes of Health. The clinical trial portion of the study also received support from Bausch & Lomb Pharmaceuticals and was completed in October 2001. Learn about the results of the clinical trial on the National Eye Institute’s website: http://www.nei.nih.gov/amd/.
The Wistar Institute
The Wistar Institute collection at Coriell contains cell lines that have been developed by Wistar scientists. These materials are offered for non-commercial research conducted by universities, government agencies and academic research centers. The Wistar Institute collection currently contains a group of hybridomas that produce monoclonal antibodies that are useful in influenza research and vaccine development. Melanoma cell lines, derived from patients with a wide range of disease ranging from mild dysplasia to advanced metastatic cancer, will be added shortly. More information on The Wistar Institute, its research and scientists can be found at www.wistar.org.
J. Craig Venter Institute Human Reference Genome (HuRef)
The Human Reference Genetic Material Repository makes available DNA from a single individual, J. Craig Venter, whose genome has been sequenced and assembled. The DNA samples are prepared from a lymphoblastoid cell line established at Coriell Cell Repositories from a sample of peripheral blood. The DNA samples are available in 50 microgram aliquots. The lymphoblastoid cell line is not available for distribution..
Read Full Post »